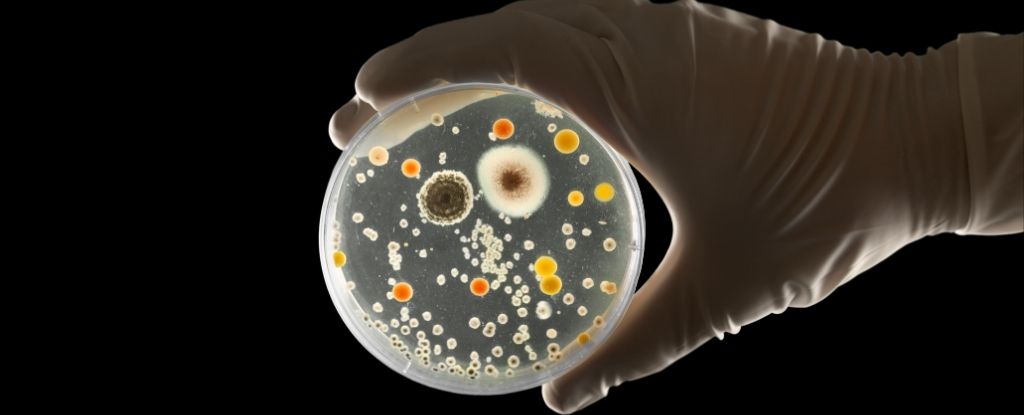
Featured image for "Unveiling the Source of Post-Surgery Infections: The Role of Skin Bacteria"

Superbug Candida auris Spreading Rapidly Across US, Experts Warn
A deadly, drug-resistant fungus called Candida auris is spreading globally, particularly in U.S. hospitals, posing a significant health threat due to its resistance to multiple antifungal drugs and ability to spread on surfaces and equipment. Researchers warn that current diagnostics and treatments lag behind the fungus's evolution, emphasizing the urgent need for new antifungal agents, improved detection, and increased awareness, especially in resource-poor countries. Despite challenges, recent studies suggest potential vulnerabilities in the fungus that could lead to new treatment strategies.